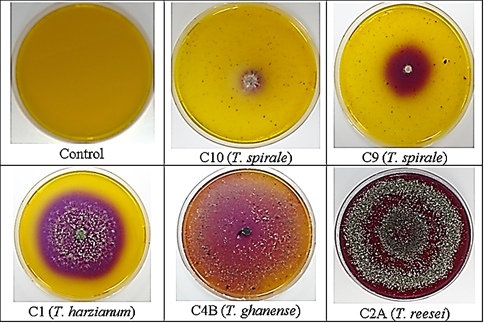

1. Introduction
The rise in population over the decades has necessitated meeting a significant food demand, leading to the expansion of substantial areas dedicated to commercial crops. Consequently, enhancing agricultural yield, growth, or production has become imperative, prompting the utilization of broad-spectrum chemical fertilizers, which have even approached the permissible human limit. (Gladek et al., 2017).
In sustainable agricultural practices, the management of plant diseases is crucial; various fungi from different genera have proven to be efficient biocontrol agents against phytopathogenic fungi, with Trichoderma standing out for its extensive use in agriculture (Guzmán-Guzmán et al., 2023). Incorporating these biocontrol agents into farming practices contributes to environmentally friendly disease management strategies, facilitating decreased chemical usage and promoting a more sustainable approach to preserving crop health (El-Saadony et al., 2022; Yao et al., 2023).
Meanwhile, in the pursuit of solutions to address the impending population growth and the pressing need for field practices aligned with food safety regulations, pertinent information has emerged regarding the efficacy of biocontrollers, in the case of utilizing microencapsulated derived from Trichoderma isolates, which has proven to be a valuable strategy in managing diseases, notably effective against Moniliopthora roreri. This pathogen has posed a significant threat to cocoa crops, particularly in countries like Ecuador and Colombia, where it has caused substantial damage (Valenzuela-Cobos et al., 2023). Applying these beneficial fungi through microencapsulation has shown promising results (Qi et al., 2023), significantly mitigating the development of the disease and providing a practical solution to combat the destructive impact of Moniliopthora roreri on cocoa cultivation.
This innovative approach not only demonstrates the efficacy of Trichoderma isolates but also underscores the potential of microencapsulation as a targeted and efficient delivery method for enhancing the biocontrol capabilities of beneficial fungi in agriculture (Avilés et al., 2023; Maruyama et al., 2020).
Phytochemical studies have delved into compounds that function as biocontrol agents. Recent studies reveal that the inhibitory activity may be associated with various chemical components, including alkaloids, lactones, quinones, flavonoids, and antifungal compounds. Some examples identified through gas chromatography-mass spectrometry include widdrol, β-caryophyllene, tyrosol, isobutyrate, and butyl sorbic acid. This extensive examination sheds light on the diverse chemical mechanisms underlying the inhibitory effects, offering valuable insights into the potential applications of these bioactive compounds in agricultural disease management (Chóez-Guaranda et al., 2023).
In addition to acting as defenders against diverse pathogens, fungal biocontrol agents safeguard plants from various forms of abiotic stress, supporting plant growth and production (Fazeli-Nasab et al., 2022). An additional aspect regarding Trichoderma is the potential utilization of its various secondary metabolites. These metabolites have chemical characteristics that have attracted significant attention in the industrial, pharmaceutical, and food sectors (Zhang et al., 2021). Consequently, numerous studies are currently being carried out to explore the various metabolites and discover their excellent efficacy against phytopathogens (Guo et al., 2023; Khan et al., 2020). This exploration not only underlines the versatility of Trichoderma but also hints at its promising applications in various industries, showing its potential as a valuable resource for developing novel products with agricultural, medical, or food-related benefits.
This review presents an overview of the present status and historical development of Trichoderma spp., highlighting the importance of employing bioinputs as a biotechnological tool for enhancing agriculture. It underscores the validation and promotion of genetic improvement in various strains of filamentous fungi through molecular mechanisms to achieve advancements in plant growth and to improve their resilience against phytopathogenic agents.
2. Overview of Trichoderma spp
The species of the genus Trichoderma have rapid growth, showing green conidia with a branched structure (Schmoll et al., 2010) (Figure 1). They are present in agricultural soils and forests, encompassing diverse lifestyles and interactions with other organisms or adapting to inhospitable and sterile soils such as bioreactors or fermenters, which makes them attractive in the current climate change environment (Yao et al., 2023).
Along with their different roles in various habitats, Trichoderma strains have been described as biological controllers of diseases caused by pathogens in different crops due to their other mechanisms of action (Figure 2) (Galarza et al., 2015; Yao et al., 2023). These mechanisms recognize the attack by pathogens through the rupture of the cell wall and the absorption of the released nutrients, denominated mycoparasitism (Tyśkiewicz et al., 2022). This interaction with pathogens induces the local or systemic resistance of the plant (elicitors, endoelicitors, exoelicitors) and mainly in the secretion of enzymes and secondary metabolites; each strain may have its mechanism of interaction between the pathogen and the host plant (Tyśkiewicz et al., 2022; Zin et al., 2020).
The Trichoderma genus involved several species with bioprospecting and biotechnology applications focused on the high capacity of enzyme production, with different applications, especially in agriculture to control plant pathogen disease, in biofuel production, degradation of clothing in the textile industry (Abd et al., 2018; Carvalho et al., 2017). The significance and potential environmental impact of specific genes have prompted a shift towards sustainable alternatives in agriculture. Given the widespread use of synthetic products like herbicides and fertilizers, which may pose environmental and health risks, there is a growing interest in exploring natural solutions (Çakmakçı et al., 2023). Trichoderma, known for its remarkable adaptive capacity to diverse environmental conditions, has emerged as a promising source of metabolites and bio-controllers (Sandle, 2014). These alternatives offer effective pest and pathogen control and align with the principles of environmentally friendly and sustainable agriculture (Abdul-Halim et al., 2023).
In practical terms, research has demonstrated the inhibitory activity of Trichoderma species, particularly Trichoderma asperellum and Trichoderma atroviride, against various pathogens such as Fusarium and Aspergillus. These pathogens have been responsible for significant agricultural losses (Guzmán-Guzmán et al., 2023). Using Trichoderma-based solutions presents a valuable opportunity to mitigate the adverse effects of harmful synthetic chemicals, contributing to the development of more eco-friendly and resilient agricultural practices. (Stracquadanio et al., 2020).
In other aspects, some varieties of Trichoderma have been used to combat diseases in cocoa (Theobroma cacao), such as Vascular streak dieback (VSD) caused by Oncobasidium theobromae due to the high potentiality of the secondary metabolites in combination with organic fertilizers (Rosmana et al., 2019). Excellent results have been achieved in terms of the growth of the plants and the number of shoots (Simamora et al., 2021).
In addition, the perspectives of Trichoderma use in different areas lead to improving or optimizing the application of the other species of this genus. Genome analysis of various species revealed a pool of chitinolytic enzymes produced in different stages of the fungus life cycle (Chung et al., 2022). The number of biosynthetic pathways Trichoderma uses to generate other compounds is due to the complexity of its genome (Schalamun et al., 2022). The molecular processes of sequencing and annotation of the Trichoderma reesei genome began further research on this beneficial fungus (Martinez et al., 2008); more than 25 Trichoderma genomes have been added (Kubicek et al.,2019; Mukherjee et al., 2013). Likewise, the genomic studies of this genus were based on genes related to the production of enzymes to obtain biofuel, while T. reesei has been one of the most studied species, which was transformed by selection methods, getting the strain RUT-C30 which produced a high amount of extracellular cellulose (De Paula et al., 2018).
Consequently, and due to its significant capacity to produce enzymes, this species has received Generally Recognized as Safe (GRAS) status granted by the US Food and Drug Administration US Department of Health and Human Services (Liu et al., 2023; Paloheimo et al., 2016). On the other hand, several methodologies have been imple mented to understand the different mechanisms used by this genus. Different Trichoderma strains have been transformed over time using the polyethylene glycol (PEG), CaCl2, method biolistic (Lorito et al., 1993), electroporation (Goldman et al., 1990), shock waves (Magaña-Ortíz et al., 2013), as well as transformation by Agrobacterium tumefaciens (Zeilinger, 2004) (Figure 3).
T. reesei is a filamentous fungus, and it is among the Trichoderma strains with the most significant utility in the industrial field due to the production of cellulases, hemicellulases, and recombinant proteins (Wu et al., 2019) serving as a host organism to produce recombinant enzymes is one of its prominent applications (Arai et al., 2023). Much of these are used to depolymerize biomass into simple sugars, converted into intermediate chemicals and biofuels, such as ethanol (Martinez et al., 2008; Xu et al., 2015). Similarly, T. reesei has been employed in the biodelignification and subsequent enzymatic hydrolysis of Elephant grass, thereby enabling bioethanol production (Iyyappan et al., 2023).
Recently, with the development of omics tools, it was possible to advance with different studies related to the physiology and biology of the fungus, which is integrated into a biotechnological system looking for complex interactions in the production of enzymes by the strains of the Trichoderma genus, through molecular transformations tools (Cai et al., 2021;Wang et al., 2022). Additionally, genomic, transcriptomic, and proteomic studies allow the characterization and identification of Trichoderma strains related to different applications, increasing our knowledge about the biology of this genus (Wilson et al., 2009).
3. Genomic research
Twenty-five genomic sequences are available from species of the genus Trichoderma, which have opened a range of possibilities to deepen the benefits of the species belonging further genetically to this genus. With the aid of this information, functional analysis of predicted genes involved in the biological processes of the beneficial fungus is needed. The functional characterization of the genes involved in these processes could be performed through knockouts of the different genes. In addition to studying proteins, identification focuses on the interaction routes, including genetic overexpression. Additionally, gene substitution using homologous recombination is considered one of the most used methodologies for characterizing genes of the species under study (Kück et al., 2010).
Analyzes dedicated to the function of the genes of the beneficial Trichoderma species are generally attributed to the construction of recombinant DNA using conventional cloning techniques, which are based on digestion and ligation procedures. This general vector technique for creating deletions or overexpressing mutant strains of genes is considered a technique or methodology that generates disadvantages (Fitz et al., 2018). In contrast, the metabolite's production of enzymes by the Trichoderma genus is one of the primary factors in using this beneficial fungus in several industries.
In this sense, knowing the pathways involved in making this kind of compound is essential. Additionally, in general, two genes could be involved in metabolic pathways; one gene plays a role in the inactivation of the path, while the other gene could be involved in the production of target molecules (Saravanakumar et al., 2020), which could generate the independent activation of a gene that participates precisely in the production of metabolites (Steen et al., 2010).
Likewise, within the production of microbial metabolites, the coenzymes NADH, ATP, and NADPH are related, which could trigger the production of primary metabolites. Therefore, the genetic modification of the genes associated with the expression of coenzymes would increase the production of metabolites (Zhang et al., 2007). Finally, to avoid inhibiting the growth of a microorganism, the production of metabolites must be generated in time (Yazawa et al., 2013). The genomic organization, together with the regulation and enzymatic hydrolytic expression in the Trichoderma harzianum strain IOC3844, are closely related, which helps to increase plant degradation (Ferreira Filho et al., 2020).
On the other hand, the Trichoderma genus produces many volatile compounds and enzymes, such as glucanases, chitinases, and proteases (Stoppacher et al., 2010) (Figure 4). The production of enzymes is related to the expression of a battery of genes. Among the species whose genes are associated with the production of enzymes have been characterized and identified, T. harzianum is related to the production of GlcNAcases, while T. atroviride and T. virens are related to the functional genes exc1, exc2, tvnag1, and tvnag2, chi33, chi37, and chi42 (Harman et al., 2004; Howell, 2003).
The genes bgn131, lam1.3, and glu78 are also responsible for glucanase production in the T. harzianum strain (Donzelli et al., 2001). In addition, the genes Prb1 and tvsp1 are related to protease production in the species above. The same author mentioned that T. atroviride and T. virens produce glucanases involved with the genes Tv-bgn1 and Tv-bgn2. Similarly, it was reported that the gene responsible for synthesizing trypsin-like acidic serine peptidase in the T. harzianum strain is pra1 (Suarez et al., 2004). Regarding the mycoparasitism of T. harzianum (Szabó et al., 2013) express that there are genes that are co-expressed during these mechanisms of action, including the sedolisin serine protease p5216, the acidic serine protease pra1, aspartic proteases p6281 and the metalloendopeptidase p7455.
Regarding the secretion of secondary metabolites by the different species of this beneficial fungus, the tex1 gene is mentioned, which is involved in synthesizing peptaiboltrichovirin II (Wiest et al., 2002). In addition, in the T. virens strain, several genes were identified that are related to the production of peptaibol synthetase, including tex1, tex2, and tex3. Furthermore, SirP and GliP clusters are associated with the synthesis of epidithio-dioxopiperazines. The tri5 gene is related to the synthesis of trichothecene; likewise, this strain may have a gene similar to SirP, which is associated with the production of secondary metabolites that have not yet been identified (Howell et al., 2008; Mukherjee et al., 2012).
On the other hand, the T. reesei species faces the presence of the GliP cluster, even though this species does not produce gliotoxin. Several PKS genes have been described in different strains; in the T. harzianum case, ksT-1 and pksT-2 have been reported (Yao et al., 2016). On the other hand, the deletion in a T. reesei strain in the pks4 gene affected processes such as conidia pigmentation, the production of secondary metabolites, and the stability of the cell wall, as well as the antagonistic capacity of the beneficial strain (Atanasova et al., 2013).
4. Genetic Improvement of Trichoderma
Using molecular techniques to develop different stable and reproducible modifications in various microorganism's genomes has benefited both the agricultural and industrial sectors. The Trichoderma genus is known for the highest production of cellulolytic enzymes, such as proteases, cellulases, hemicelluloses, xylanases, amylases, and cellobiohydrolase, in addition to secondary metabolites with pharmacological properties, such as gliotoxin and gliovirin, peptaibols, polyketides, siderophores, pyrons, and terpenoids/steroids (Mukherjee, Buensanteai, et al. 2012; Zeilinger et al., 2016).
One of the most common techniques is genetic transformation through protoplasts mediated by Agrobacterium tumefaciens (Wang et al., 2019); however, initially for transforming Trichoderma, techniques including electroporation or biolistic were used (Schuster et al., 2016). T. reesei has excellent protein production capacity compared to other microbial systems such as Saccharomyces cerevisiae and Escherichia coli. Due to this, there is great interest in improving these strains for industrial applications in increasing biomass and biofuel production (Martinez et al., 2008).
Table 1 CRISPR technology applied to Trichoderma
| Technological tool | Method | Genetic improvement | Reference |
|---|---|---|---|
| Crispr Cas9 | Vector expression | Loss of pigmentation of the conidia due to the disruption of the pks4 and ku70 genes involved in melanin synthesis | Cortes et al., 2023 |
| Biolistic transformation | Mutants obtained with an auxotrophic marker, phenotypic characterization demonstrated a reduction in the growth of the mutants in the absence of uridine, as well as resistance to 5-fluorotic acid | Vieira et al., 2021 |
Furthermore, although the T. reesei genome has been sequenced (Li et al., 2017), little-studied cellular functions are essential in different gene biological pathways. However, despite the multiple utilities of this fungus, some factors limit the production of these enzymes. One of them is the pH since it must be acidic for high enzymatic activity; otherwise, it will diminish Trichoderma activity (Wang et al., 2014). These reasons have led to the development several molecular techniques to increase or maintain the production of enzymes and proteins in T. reesei and other Trichoderma species under different test conditions.
The primary industries for using Trichoderma come from the agricultural sector, so the mechanisms of action focused on knowing and studying various beneficial strains on pathogenic strains and the genetic transformation of indicator genes, including genes that code for green fluorescents protein (GFP) and β-glucuronidase (GUS), which are widely used to analyze the activity of different beneficial genes, especially in agricultural settings (Bae et al.,2000; Green et al., 1995) (Figure 5).
Regarding the improvements of the strains of the beneficial fungus, there are different methodologies widely used to date, including Agrobacterium-mediated transformation, protoplasts, polymerase chain reaction (PCR), SceI meganuclease, zinc finger nuclease, RNA silencing (RNAi), transcription activator-like effector nuclease (TALENs) and more recently the use of CRISPR-Cas9 in filamentous fungi (Shi et al., 2017) (Table 1).
In the transformation mediated by Agrobacterium tumefaciens, only a fraction of the plasmid DNA is randomly integrated into the fungal genome, conferring a transformation efficiency of 100 to 1000 times more than other conventional methods (Cardoza et al., 2006). Another alternative is using vectors or recombinant plasmids to find strategies to explore various gene functions. This process has disadvantages: cloning and ligating the plasmid or inserting it in different genome sites. Recombination efficiency in filamentous fungi is generally low at 5%, with a low percentage of genetic markers (Kück et al., 2010). Various investigations have been carried out to overcome these limitations, such as cloning processes, including Gateway and Golden Gate (Nogueira-López et al., 2019), or as previously mentioned, transformation with protoplasts also results in a widely used technique, where its efficiency ranges between 1 and 103 transformants/µg of DNA (Li et al., 2017).
In turn, this situation has meant a significant advance in our attempt to modify fungal strains genetically, allowing scientists to seek new techniques that enable greater specificity between the different existing fungal strains (Martín, 2015). The rapid progress and broad application of a versatile genome editing technology, namely the CRISPR (regularly interspaced clustered short palindromic repeat)-Cas9 (CRISPR-related nuclease 9) system, revolutionized biological research and has many innovative applications in a wide range of fields that show great promise in the study and application of filamentous fungi such as Trichoderma (Wang et al., 2022).
The CRISPR-Cas9 tool was first used in the T. reesei strain through gRNA by in vitro transformation (Li et al., 2017) (Liu et al., 2015), and gene disruption was achieved through direct in vitro transformation by assembling a complete Cas9/gRNA in the T. reesei strain (Hao and Su, 2019; Rantasalo et al., 2019). However, expression during in vitro gRNA synthesis is not convenient, and the stability of gRNA during transformation could influence the efficiency of genomic editing (Pohl et al., 2016). On the other hand, the gRNA system in different species of filamentous fungi is driven by the RNA polymerase III motor, such as the U6 promoter. Additionally, the U6 snRNA promoter has been widely used in gRNA transcription during transcription using the CRISPR-Cas9 system (Arazoe et al., 2015; Katayama et al., 2016; Zhang et al., 2016; Zhang et al., 2016). Wu et al. (2020) performed in vivo transcription using gRNA synthesized under the control of T. reesei snRNA promoters, causing a ura5 frameshift mutation through non-homologous recombination events presenting a simple editing method of genes using an in vivo gRNA transcription system coupled to CRISPR-CAS9 (Wu et al., 2020).
In the view to reduce undesired enzyme production from T. reesei, three significant cellulitic genes, cellobiohydrolase II (cbh2), endonuclease I and II (egl1 and egl2, respectively), were deleted and replaced with lipase B from Candida Antarctic CalB gene (Rantasalo et al., 2019). On the other hand, T. harzianum is recognized for its various agricultural applications, produces 6-pentyl-pyrone on the transformed strain through the THCTF1 factor, different from the ThMBF1 transcription coactivator which was overexpressed into T. harzianum, causing decrease on the antifungal activity against Fusarium oxysporum and Botrytis cinereal (Rubio et al., 2017).
The study of different genes of Trichoderma strains and their applications are patented for use as biofungicides and in different breeding strategies. Gene editing technologies are essential for genetically characterizing this species, although they are still being researched. What has been confirmed are several mutants obtained employing an additional marker in this species using the CRISPR system, biolistically verifying that the alteration of the pyr4 gene does not interfere with the activity of biological control of pathogens (Vieira et al., 2021).
5. Current and future challenges
Trichoderma has many strains that can produce a battery of high-value compounds, such as secondary metabolites and enzymes. This beneficial fungus appears as a cellular bio-factory, acting as homologous or heterologous, creating various combinations of industrial and medical importance. To have better knowledge and understanding of the biological and metabolic functions of the genus Trichoderma, through genetic engineering tools, researchers can generate genetic modifications related to the production of primary and secondary metabolites, as well as enzymes, which are involved in the homology and heterology of the genetic material of the fungus. In this sense, this chapter provides essential information on genetic manipulation tools and functional metabolomics based on different species of the genus Trichoderma related to the high production of various compounds of industrial interest. Despite significant advances, challenges remain, such as the pH sensitivity of Trichoderma, which limits enzyme activity. Ongoing research focuses on developing molecular techniques to overcome these limitations and maintain or increase enzyme and protein production under different conditions.
Conclusions
This article reviews the significance of species like Trichoderma, renowned for its rapid growth and diverse interactions in various environments, encompassing agricultural soils and specialized conditions like bioreactors or fermenters. Trichoderma employs mechanisms such as mycoparasitism, plant resistance induction, and the secretion of enzymes and secondary metabolites to combat phytopathogens.
One of its notable features is its potential in bioprospection and biotechnological applications, particularly in enzyme production for controlling pathogenic plant diseases, biofuel production, and textile industry processes. Various genetic modification techniques, including Agrobacterium-mediated transformation, protoplasts, and advanced CRISPR-Cas9 technology, enhance strains for industrial applications.
The revolutionary CRISPR-Cas9 system has transformed biological research, allowing precise genome editing in filamentous fungi like Trichoderma. This system has been successfully employed to delete and replace specific genes, thereby improving the understanding and manipulation of Trichoderma strains for diverse purposes. T. reesei as an example; its substantial utility in the industrial field stems from its production of cellulases, hemicellulases, and recombinant proteins. Each of these benefits has significantly been amplified with the gene editing system. Trichoderma is an environmentally friendly alternative, contributing to more ecological and resilient agricultural practices.
In conclusion, the text highlights the multifaceted nature of Trichoderma, emphasizing the im portance of genetic exploration, functional analysis, and advanced molecular techniques in unlocking its potential for various applications. Ongoing advancements in genetic modification technologies, particularly CRISPR-Cas9, offer promising prospects for further enhancing and tailoring Trichoderma strains to specific needs, from agriculture to industrial processes.